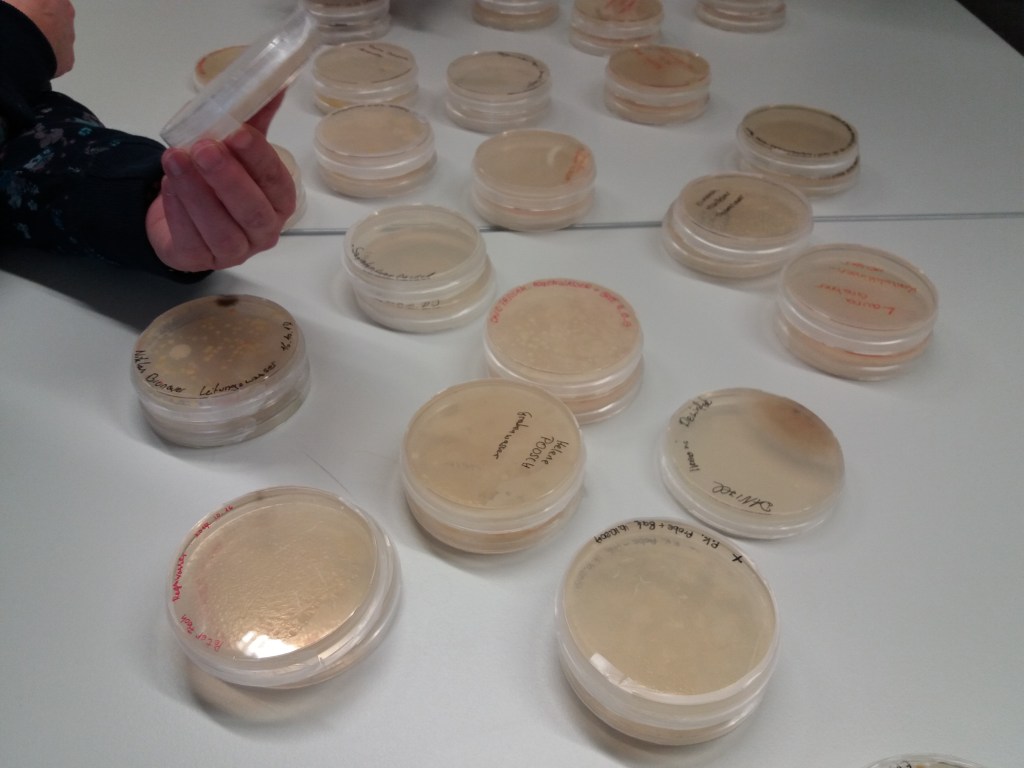

Am 6. November 2017 absolvierte die 6C den 2.Teil ihres Sparkling Science Projekts.
Dieses Mal haben wir richtig wissenschaftlich gearbeitet. Es ging darum, neue unentdeckte Bakterienarten in heimischen Gewässern zu finden.
Dafür haben alle von uns Wasserproben aus den unterschiedlichsten Gewässern in Salzburg mitgebracht. Die Proben haben wir dann gefiltert und auf Agarplatten ausgestrichen. Uns wurde erklärt, dass das Institut jetzt 2 Jahre mit diesen Proben arbeiten wird, um zu erforschen, welche Bakterienkulturen wachsen und ob vielleicht noch nicht beschriebene Arten entdeckt werden können.
Weiters haben wir uns die Bakterienzuchten vom letzten Workshop angesehen, wo es darum ging, in welchen Flüssigkeiten wir Bakterien vermuten. Die Ergebnisse waren zu einem Großteil sehr überraschend. Kaum einer von uns hätte erwartet, dass der Unterschied zwischen abgekochtem und nicht abgekochtem Wasser so groß ist. Ebenso erschreckend war die Ansammlung an Bakterien in der Milch.
Mir hat dieses Projekt sehr gut gefallen, da ich viel Interessantes über Bakterien lernen konnte.
Luna Deusch